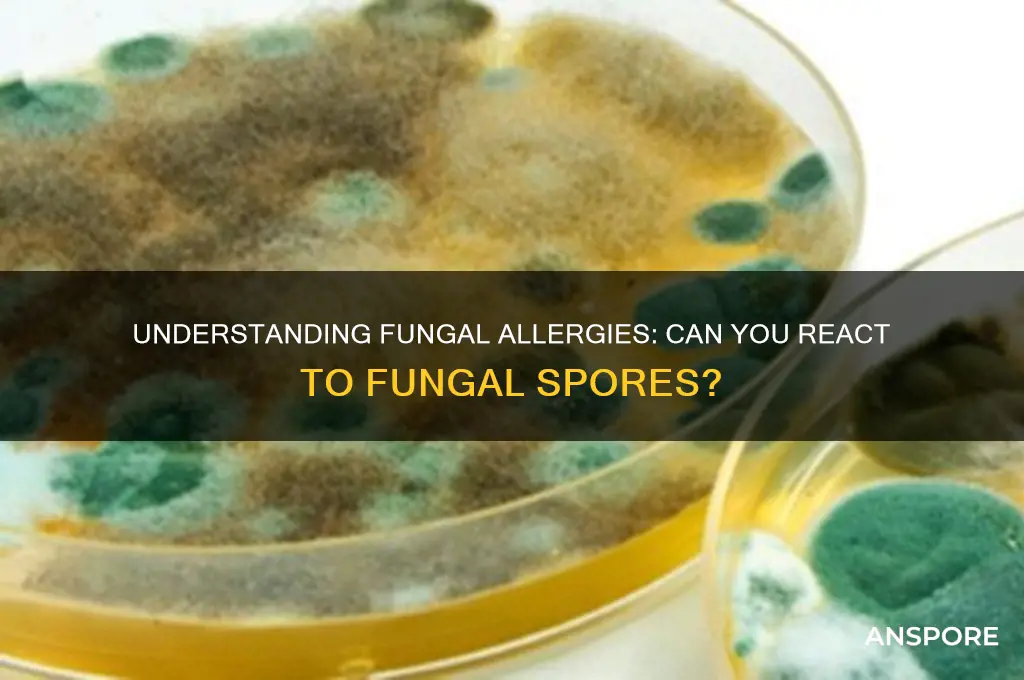
can you be allergic to fungal spores

Fungal spores are microscopic particles released by fungi as part of their reproductive process, and while they are ubiquitous in the environment, they can pose health risks to certain individuals. Allergies to fungal spores, often referred to as mold allergies, occur when the immune system overreacts to these spores, mistaking them for harmful invaders. Symptoms can range from mild, such as sneezing, runny nose, and itchy eyes, to more severe reactions like asthma exacerbations or fungal sinusitis. Common allergenic fungi include *Cladosporium*, *Aspergillus*, *Alternaria*, and *Penicillium*, which thrive in damp, humid environments. Understanding the prevalence and impact of fungal spore allergies is crucial, as exposure can be difficult to avoid, particularly in areas with high mold counts or water-damaged buildings. Diagnosis typically involves skin prick tests or blood tests to identify specific fungal allergens, and management often includes environmental controls, medications, and, in some cases, immunotherapy.
| Characteristics | Values |
|---|---|
| Allergic Reaction to Fungal Spores | Yes, individuals can be allergic to fungal spores, which are microscopic particles released by fungi for reproduction. |
| Common Fungi Involved | Alternaria, Cladosporium, Aspergillus, Penicillium, and Candida. |
| Symptoms | Sneezing, runny or stuffy nose, itchy eyes, skin rashes, coughing, wheezing, and asthma exacerbations. |
| Risk Factors | Pre-existing asthma, weakened immune system, occupational exposure (e.g., farmers, bakers), and living in damp environments. |
| Diagnosis | Skin prick tests, blood tests (specific IgE antibodies), and allergy symptom history. |
| Prevention | Reduce indoor humidity, fix leaks, use dehumidifiers, clean moldy areas, and avoid outdoor activities during high spore counts. |
| Treatment | Antihistamines, nasal corticosteroids, decongestants, immunotherapy (allergy shots), and asthma medications if applicable. |
| Prevalence | Estimated to affect 5-10% of the population, with higher rates in humid climates. |
| Seasonality | Spores are more prevalent in warm, humid weather, typically peaking in late summer and early fall. |
| Cross-Reactivity | Some individuals may experience cross-reactivity between fungal spores and certain foods (e.g., mushrooms). |
Explore related products
What You'll Learn

Common Fungal Allergens
Fungal spores are a common yet often overlooked trigger for allergies, affecting individuals across various age groups and environments. These microscopic particles, released by fungi to reproduce, can become airborne and inhaled, leading to allergic reactions in sensitive individuals. Unlike pollen allergies, which are seasonal, fungal allergies can persist year-round, especially in damp or mold-prone areas. Understanding the specific fungal allergens is crucial for effective management and prevention.
One of the most prevalent fungal allergens is *Aspergillus*, a mold genus commonly found indoors and outdoors. It thrives in decaying organic matter, such as compost piles, and can also grow on household surfaces like walls and carpets in humid conditions. Exposure to *Aspergillus* spores can cause allergic bronchopulmonary aspergillosis (ABPA), a condition often seen in individuals with asthma or cystic fibrosis. Symptoms include wheezing, coughing, and shortness of breath. Reducing indoor humidity below 50% and using HEPA air filters can significantly minimize exposure to these spores.
Another notable fungal allergen is *Alternaria*, a mold frequently found in soil, plants, and damp environments. It is one of the most common outdoor molds and is particularly prevalent during late summer and early fall. *Alternaria* spores are a leading cause of allergic rhinitis and asthma exacerbations, especially in children and adults with pre-existing respiratory conditions. Regularly cleaning gutters, removing decaying leaves, and using mold-resistant products in bathrooms and basements can help limit exposure.
For those with severe fungal allergies, immunotherapy may be a viable option. Allergy shots containing fungal extracts can desensitize the immune system over time, reducing the severity of reactions. However, this treatment requires careful monitoring by an allergist and is typically reserved for cases where environmental controls are insufficient. Additionally, antifungal medications may be prescribed to treat underlying fungal infections that exacerbate allergic symptoms.
Practical tips for managing fungal allergies include maintaining proper ventilation in homes, promptly fixing leaks, and avoiding activities that increase spore exposure, such as raking leaves or working with soil without a mask. For individuals with known sensitivities, monitoring local mold spore counts and staying indoors during peak periods can be beneficial. By identifying specific fungal allergens and implementing targeted strategies, those affected can achieve better control over their symptoms and improve their quality of life.
Do Dead Mold Spores Impact Analysis Results? A Detailed Look
You may want to see also

Symptoms of Fungal Allergies
Fungal spores are everywhere, floating in the air we breathe, yet only a fraction of individuals react adversely to their presence. For those sensitive to these microscopic particles, the symptoms can range from mildly irritating to severely debilitating. Understanding these reactions is the first step in managing fungal allergies effectively.
Identifying the Symptoms: A Checklist for Concern
Allergic reactions to fungal spores often mimic those of other respiratory allergies, making them easy to misdiagnose. Common symptoms include sneezing, nasal congestion, itchy or watery eyes, and a persistent cough. More severe cases may present as asthma-like symptoms: wheezing, shortness of breath, and chest tightness. Skin reactions, such as rashes or hives, can also occur, particularly in individuals with atopic dermatitis. If these symptoms worsen in damp environments (e.g., basements, bathrooms, or outdoor areas with decaying leaves), fungal spores may be the culprit.
The Role of Environment: When and Where Symptoms Strike
Fungal allergies are highly context-dependent, with symptoms often flaring in specific conditions. Indoor environments with high humidity (above 50%) or water damage are breeding grounds for mold, a common source of fungal spores. Outdoor exposure peaks in late summer and fall when fungi release spores to reproduce. Tracking symptom patterns in relation to location and season can help pinpoint fungal allergies. For instance, if allergies worsen during leaf-raking season or in a moldy basement, fungal spores are likely the trigger.
From Mild to Severe: Grading the Impact
The severity of fungal allergy symptoms varies widely. Mild cases may cause occasional discomfort, while severe reactions can disrupt daily life. Chronic exposure can lead to long-term complications, such as sinus infections or bronchial inflammation. Children, the elderly, and immunocompromised individuals are particularly vulnerable. For example, a study found that 30% of asthma cases in children are linked to mold exposure. Recognizing the spectrum of symptoms allows for timely intervention, from over-the-counter antihistamines to prescribed immunotherapy.
Practical Tips for Symptom Management
Reducing exposure is key to managing fungal allergies. Use dehumidifiers to keep indoor humidity below 40%, and promptly repair leaks or water damage. Wear a mask when cleaning moldy areas or working outdoors in spore-heavy seasons. HEPA air filters can trap fungal spores, improving indoor air quality. For persistent symptoms, consult an allergist for testing and tailored treatment plans. Nasal corticosteroids or allergy shots may be recommended for long-term relief. By combining environmental control with medical intervention, individuals can minimize the impact of fungal allergies on their health.
Are Spores Legal in NYC? Understanding the Current Laws and Regulations
You may want to see also

Diagnosis Methods
Fungal spore allergies, though less commonly discussed than pollen or pet dander allergies, can cause significant discomfort and health issues. Diagnosing these allergies requires a systematic approach to identify the specific fungal triggers and their impact on the individual. Here’s how healthcare professionals typically proceed.
Step 1: Medical History and Symptom Analysis
Begin with a detailed medical history, focusing on symptoms such as sneezing, coughing, nasal congestion, skin rashes, or asthma-like symptoms, especially in damp or mold-prone environments. Note seasonal patterns or exposure to areas with high fungal spore counts, like basements, gardens, or compost piles. For instance, symptoms worsening during rainy seasons or after cleaning moldy spaces are red flags. This initial assessment helps narrow down the likelihood of a fungal spore allergy before proceeding to more specific tests.
Step 2: Skin Prick Testing
One of the most common diagnostic tools is the skin prick test. A small amount of fungal spore extract is applied to the skin, which is then pricked to allow the allergen to enter. If a raised, itchy bump (wheal) appears within 15–20 minutes, it indicates a positive reaction. This test is quick, cost-effective, and can identify allergies to specific fungi like *Alternaria* or *Cladosporium*. However, it may not be suitable for individuals with severe skin conditions or those on antihistamines, which can interfere with results.
Step 3: Blood Tests (Specific IgE Antibody Testing)
For those unable to undergo skin testing, blood tests like the ImmunoCAP Specific IgE test measure the level of immunoglobulin E (IgE) antibodies in response to fungal allergens. A blood sample is taken and analyzed in a lab, with results typically available within a week. While less immediate than skin testing, this method is useful for confirming sensitivities to specific fungal species. Normal IgE levels range from 0–0.35 kU/L, with values above 0.70 kU/L indicating a likely allergy.
Cautions and Considerations
False positives or negatives can occur in both skin and blood tests, so results should be interpreted alongside clinical history. Additionally, fungal spore allergies often coexist with other allergies or asthma, complicating diagnosis. Cross-reactivity with other allergens, such as certain foods (e.g., mushrooms), can also muddy the waters. For children under 5, skin testing may be less reliable due to immature immune responses, making blood tests a preferred option.
Diagnosing fungal spore allergies requires a combination of clinical evaluation, skin prick testing, and blood tests, tailored to the patient’s age, symptoms, and medical history. Early and accurate diagnosis is crucial for effective management, which may include allergen avoidance, medications, or immunotherapy. By identifying the specific fungal triggers, individuals can take proactive steps to minimize exposure and improve their quality of life.
Are Purple Spore Syringes Better? Unraveling the Myth and Facts
You may want to see also
Explore related products

Prevention Strategies
Fungal spore allergies, though less commonly discussed than pollen allergies, can significantly impact quality of life. Prevention hinges on minimizing exposure to these microscopic irritants, which thrive in damp, organic environments.
Step 1: Control Indoor Humidity
Maintain indoor humidity below 50% using dehumidifiers, particularly in basements, bathrooms, and kitchens. Mold spores proliferate in moisture-rich areas, so regularly check hidden spaces like under sinks, behind walls, and inside air conditioning units. For optimal results, invest in a hygrometer to monitor levels and empty dehumidifier trays daily to prevent stagnant water buildup.
Step 2: Ventilate and Clean Strategically
Improve air circulation by opening windows during dry weather and using exhaust fans in high-moisture areas. HEPA filters in HVAC systems trap spores effectively, but replace filters every 1–3 months. Weekly vacuuming with a HEPA-filtered device reduces spore accumulation in carpets and upholstery. Avoid carpeting in damp-prone zones like bathrooms or basements, opting instead for tile or hardwood.
Step 3: Target Outdoor Exposure
Fungal spores peak in outdoor air during warm, humid seasons, often after rainfall. Limit outdoor activities during these conditions, especially in areas with decaying leaves or compost piles. If exposure is unavoidable, wear an N95 mask and shower immediately afterward to remove spores from skin and hair. For gardeners, use gloves and long sleeves when handling soil or mulch, and avoid disturbing leaf piles.
Step 4: Monitor and Treat High-Risk Areas
Regularly inspect houseplants for mold on soil surfaces; apply a thin layer of aquarium gravel to inhibit spore growth. In food storage, discard moldy items immediately and clean containers with a 1:10 bleach-water solution. For individuals with severe allergies, consider professional mold remediation for persistent infestations.
By combining environmental vigilance with targeted habits, individuals can drastically reduce fungal spore exposure, alleviating allergic symptoms and improving respiratory health. Consistency in these practices is key, as spores are ever-present but manageable with proactive measures.
Effective Mold Removal: Cleaning Clothes Exposed to Mold Spores
You may want to see also

Treatment Options
Fungal spore allergies, though less commonly discussed than pollen or pet dander allergies, can cause significant discomfort, including sneezing, itching, and respiratory issues. Treatment options vary depending on the severity of symptoms and the individual’s overall health. The first line of defense is often environmental control, which involves minimizing exposure to fungal spores. This includes keeping indoor humidity below 50%, using HEPA air filters, and avoiding areas prone to mold growth, such as damp basements or compost piles. For those with persistent symptoms, medical interventions become necessary.
Antihistamines, such as loratadine (10 mg daily) or cetirizine (5–10 mg daily), are commonly prescribed to alleviate itching, sneezing, and runny nose. These medications block histamine receptors, reducing allergic reactions. For nasal congestion, nasal corticosteroids like fluticasone (50–200 mcg per nostril daily) are highly effective. They reduce inflammation in the nasal passages and are safe for long-term use. In cases of severe or persistent symptoms, immunotherapy may be recommended. Allergy shots, administered over 3–5 years, desensitize the immune system to fungal spores, offering long-term relief. Subcutaneous immunotherapy involves injections every 2–4 weeks, while sublingual tablets are a newer, needle-free alternative taken daily.
For individuals with asthma triggered by fungal spores, inhaled corticosteroids (e.g., fluticasone 100–250 mcg twice daily) are crucial to control airway inflammation. Bronchodilators, such as albuterol (90 mcg per puff as needed), provide quick relief during acute episodes. It’s essential to monitor lung function regularly and adjust medications under a healthcare provider’s guidance. Children and older adults may require lower dosages or alternative formulations, so personalized treatment plans are key.
A comparative analysis of treatment options reveals that while medications provide symptom relief, immunotherapy addresses the root cause of the allergy. However, immunotherapy is a long-term commitment and may not be suitable for everyone. Environmental control measures, though not curative, are cost-effective and can significantly reduce the need for medication. Combining these approaches often yields the best outcomes, especially for those with moderate to severe allergies.
Practical tips for managing fungal spore allergies include wearing masks during outdoor activities in mold-prone areas, promptly fixing leaks to prevent mold growth, and regularly cleaning air conditioning systems. For those with asthma, carrying a rescue inhaler and having an asthma action plan are critical. While treatment options are diverse, the choice depends on individual needs, lifestyle, and the severity of symptoms. Consulting an allergist ensures a tailored approach, maximizing effectiveness and minimizing side effects.
Can Mold Spores Thrive Without Water? Uncovering the Truth
You may want to see also
Frequently asked questions
Yes, you can be allergic to fungal spores. Fungal spores are a common allergen and can trigger allergic reactions in sensitive individuals, similar to pollen or dust mites.
Symptoms of a fungal spore allergy include sneezing, runny or stuffy nose, itchy or watery eyes, coughing, wheezing, and skin rashes. In severe cases, it can exacerbate asthma symptoms.
To reduce exposure, keep indoor humidity below 50%, fix leaks promptly, clean moldy areas, use air purifiers with HEPA filters, avoid outdoor activities during high spore counts, and wear masks when cleaning damp or moldy spaces.

























